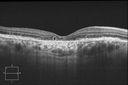
Filename=Outer_Retinal_Tubulation.JPG
Filesize=255KiB
Dimensions=750x500
Date added=May 29, 2013 Outer_Retinal_Tubulation.JPG

|
|

CHRPE lesion in the left eye - Irregular pigmentation913 views63 year old female with normal vision and CHRPE lesion in the right eye.
|
|

Equatorial Drusen Fundus Photo Left Eye913 views60-year-old woman OD 20/30, OS 20/20
|
|

913 viewsPHPV - right eye. Peripheral extension
|
|

Optic Nerve Tumor913 viewsYoung male patient with a tumor present on the optic nerve in the right eye. VA is hand motion in the right eye
|
|

Best Disease, Vitelliform Macular Dystrophy - 6 year old child912 viewsVISUAL ACUITY: Vision OD is 20/30, OS is 20/100.
|
|

Atypical Neuroretinitis - ?Ischemic - ?Paraneoplastic - Optic Nerve Swelling and Foveal Edema and Exudate912 views74-year-old woman has stage 4 non-small cell lung carcinoma decreasing vision in the left eye for at least the last two weeks, VA 10/200. Trace APD OS. No pain
|
|

Hypertensive Choroidopathy - Pheochromocytoma - Chronic Very High Blood Pressure 49 YO Male912 views49-year-old man chronic very high blood pressure sometimes the blood pressure will go as high as 260/160, sometimes it is 200/120 and sometimes it is 160/80. He has a pheochromocytoma on the adrenal gland and he has had vision loss in the right eye starting between three and four years ago.
VISUAL ACUITY: OD 20/60, OS 20/25.
|
|

Serpiginouse Choroiditis (Chorioretinitis) - Acute Right Eye - Old Left Eye VA 20/25 OD , 20/50 OS911 views63-year-old woman has serpiginous choroiditis (date - March 2011). The right eye has not been previously involved, and then she noticed new onset floaters in the right eye for the last two weeks. Her vision in the right eye is hazy because of that.
VISUAL ACUITY: Vision OD is 20/25, OS is 20/50
|
|

Retinal Tear with Vitreous Hemorrhage before and after Laser Photocoagulation911 views61-year-old man has noticed increased floaters in the right eye for about the last week. Vision OD is 20/160 There is 3+ vitreous hemorrhage with a retinal tear, about 2-disc diameters posterior to the equator at 10:00 o’clock over a retinal vessel.
|
|

Nanopthalmous (Microphthalmous) Chorioretinal Folds and Choroidal Thickening Both Eyes B-Scan Ultrasound911 views
|
|

Giant Papillary Conjunctivitis911 viewsPatient wears soft contact lenses complained of irritation when the SCL would move. Inverted eyelid in both eyes and there was papillary +2 underneath the eyelid.
|
|

Macular Hemorrhage911 viewsPatient comes in with central vision loss in the right eye. Fundus photography shows a macular hemorrhage in the central portion of the fovea. Cotton wool spots are present around the optic nerve and a little hemorrhage present inferiorily at 6-o'clock.
|
|

Acute Zonal Occult Outer Retinopathy910 views45-year-old man noticed a few years ago peripheral vision blurriness in the left eye and also some central vision loss. Previous to that, as far as he knows, the two eyes were okay.
VISUAL ACUITY: OD: 20/20; OS: 20/40.
|
|

Central Serous Retinopathy - Acute909 views49-year-old man sees a spot in the central vision with a red halo for 2 weeks OD is 20/50, OS is 20/20
|
|

Macular Scars - Laser (1980s) Ocular Histoplasmosis909 views70 year old man who had laser at Wills, Wilmer and the Mayo clinic before better therapies were available for ocular histoplasmosis related CNVM
|
|

Acute Non-arteritic Anterior Ischemic Optic Neuropathy Right Eye - Previous NA-AION left eye 909 views69-year-old man previously lost vision in the left eye from nonarteritic anterior ischemic optic neuropathy in 2006. About a week ago and noticed blurred vision in the inferonasal part of the vision in the right eye.
VISUAL ACUITY: Vision OD is 20/16, OS is 20/40
|
|

Acute Non-arteritic Anterior Ischemic Optic Neuropathy Right Eye - Previous NA-AION left eye 909 views69-year-old man previously lost vision in the left eye from nonarteritic anterior ischemic optic neuropathy in 2006. About a week ago and noticed blurred vision in the inferonasal part of the vision in the right eye.
VISUAL ACUITY: Vision OD is 20/16, OS is 20/40
|
|

Low Tension Glaucoma908 views59-year-old woman has a history of glaucoma dating back to 1990. She had trabeculectomy in the left eye in 1998 and then persisted to lose vision despite normal intraocular pressures from low-tension glaucoma in the left eye. She is now on Cosopt and Travatan in both eyes.
Vision OD is 20/20, OS is 20/16. IOP: OD 9, OS 6.
|
|

Wet AMD Fresh Submacular Hemorrhage - Displaced with Vitrectomy and Subretinal TPA908 views85-year-old woman has wet age-related macular degeneration in her better eye and she was reading with it until two days ago when she had sudden severe vision loss in the eye. Post-surgical displacment vision was 20/120.
|
|

Retinal Detachment and Macular Pucker 908 views76-year-old man has had a retinal detachment repair in the right eye. His vision was improving until just on the way over today and then his vision declined.
VISUAL ACUITY: OD 1/200
|
|

Psuedo-retinitis Pigmentosa - Bone Spicules One Eye - Probably Acute Zonal Occult Outer Retinopathy (AZOOR)908 views65-year-old woman has pseudoretinitis pigmentosa in the right eye only, most likely from acute zonal occult outer retinopathy. OD 20/25, OS 20/25
|
|

Punctate Inner Choroidopathy - PIC and Choroidal Neovascular Membrane - Right Eye - Color Fundus Photograph908 views34-year-old woman with a change in vision in the right eye about eight days ago. Her vision was hazy and she saw waviness in the vision. She does have a history of aches and pains and she was diagnosed with Sjogren’s and 2 months ago she had some fevers and some sinus drainage and that went on for about two months. She is a moderate myope. OD 20/25, OS 20/20.
|
|

Occult Maculopathy - Thin Fovea on OCT and Normal Color VA, Photos, FA VA 20/80 OU907 viewsOCT Scan Right Eye shows foveal thinning. OD is 20/80, PH 20/70; OS is 20/80, PH 20/70. His color vision is normal with 13 out of 14 correct in each eye. There is no afferent pupillary defect.
FLUORESCEIN ANGIOGRAPHY: The FA is entirely normal.
|
|

Retinoblastoma - Bilateral - Regressed - Chemotherapy, Thermal Therapy, Cryotherapy907 views10-year-old child was seen in the office on August 6, 2008. She was treated with a combination of chemotherapy at 10 months old as well as thermal therapy and cryotherapy for bilateral retinoblastoma tumors. She reportedly had nine tumors in the left eye and five tumors in the right eye
|
|

Acute Posterior Multifocal Placoid Pigment Epitheliopathy - APMPPE - Fundus Autofluorescence907 views 25-year-old man with one and half weeks ago he woke up with night chills. Also around that time his joints started hurting him. He also has headaches, although the headache at this point is not severe. His vision has been changing for about the last week and a half. He sees some spots in his vision and they are blurred spots. They are not in the central vision.
VISUAL ACUITY: OD 20/32, OS 20/32
|
|

Albinism and Foveal Hypoplasia906 views65-year-old man was told about twenty years ago by a retina specialist that he spent so much time in the sun that he burned out his maculae. He does have two brothers who have dark brown hair and he has always had white hair. He had eye exercises when he was eight or nine because of a lazy eye and his brothers, when he was little, used to call him an albino. He has been diagnosed by dermatologists as having possible albinism but he has been told by other people his skin is just fair.
VA 20/70 OU
|
|

Punctate Inner Choroidopathy - PIC and Choroidal Neovascular Membrane - Right Eye - ICG Angiogram905 views34-year-old woman with a change in vision in the right eye about eight days ago. Her vision was hazy and she saw waviness in the vision. She does have a history of aches and pains and she was diagnosed with Sjogren’s and 2 months ago she had some fevers and some sinus drainage and that went on for about two months. She is a moderate myope. OD 20/25, OS 20/20.
|
|

Central Retinal Vein Occlusion - Severe Optic Nerve Edema905 views15 yr old male presents with sudden onset of painless decreased vision in right eye x 6 days gradually worsening. No history of Trauma OD 20/30 OS 20/25, Diagnosis CRVO with ? Papillophlebitis.
|
|

RD905 viewsRD
|
|

Hemangioma905 viewsFP Composite of Hemangioma in OD
|
|

Multifocal Choroiditis and Subretinal Fibrosis - 32 yo Female Old Macular Scar OD904 views32-year-old woman vision loss in the right eye associated with macular scarring and multifocal choroiditis in 1999 with new vision loss in left eye: OD 20/400, OS 20/50.
|
|

Acute Zonal Occult Outer Retinopathy904 views45-year-old man noticed a few years ago peripheral vision blurriness in the left eye and also some central vision loss. Previous to that, as far as he knows, the two eyes were okay.
VISUAL ACUITY: OD: 20/20; OS: 20/40.
|
|

Radioactive Plaque Placement for Choroidal Melanoma Gold Plaque about the size of a Quarter904 views
|
|

Congenital Achromatopsia 904 views26-year-old man was diagnosed with congenital achromatopsia by ERG as a child. He has family members who also have this disorder. OD 20/200, OS 20/200.
|
|

Non-Foveal Geographic Atrophy Both Eyes904 views81-year-old man has age-related macular degeneration in both eyes. Vision OD is 20/40, OS is 20/80.
|
|

Asymptomatic Retinal Detachment Confirmed with Optical Coherence Tomography (OCT)904 views24-year-old 20/20 vision in each eye. Patient referred for retinoschisis. OCT confirmed retinal detachment. Patient is very active and in military so the detachment was treated with laser demarcation.
|
|

Retinal Coloboma904 viewsYoung 19-year old female with Charge Syndrome comes in for eye exam. VA is 20/400, right eye, 20/30, left eye. Fundus photography shows coloboma covering the macula and pushing the optic nerve in the right eye.
|
|

Drusen Maculopathy - Confluent Subfoveal Soft Hydrophobic Drusen - Red Free Image shows Confluent Drusen 903 views73-year-old woman. She is diabetic for thirteen years. She is also on Coumadin for her heart disease.
VISUAL ACUITY: OD 20/25, OS 20/50.
|
|

Mild Clinically Significant Diabetic Macular Edema903 views58-year-old woman diabetic for 20 years who has diabetic macular edema in both eyes. She has had waxing and waning edema in the past and I thought it might improve on its own but it did not. She notices her vision is still a little hazy.
VISUAL ACUITY: Vision OD is 20/30, OS is 20/25.
|
|
Outer Retinal Tubulation903 viewsPatient with a history of wet macular degeneration and glaucoma in both eyes. VA is 20/50, right eye, 20/80, left eye. Patient is treated with Eylea in both eyes. Enhanced Depth Imaging OCT reveals a small like form of a cyst which in fact isn't a cyst at all. This is called Outer Retinal Tubulation in which degenerating photo-receptors may become arranged in a circular or ovoid fashion. This is sometimes misdiagnosed as cystic changes in the retinal pigment epithelium or sub-retinal fluid.
|
|

902 views
|
|

Calcified Drusen - Dry Age-related Macular Degeneration - Geographic Atrophy902 views87 Year old woman with dry age-related macular degeneration in both eyes.With both eyes open she is fine, but when she closes the left eye, things are wavier.
VISUAL ACUITY: Vision OD is 20/100, OS is 20/40.
|
|

Acute Annular Outer Retinopathy - VA loss 2 days Right Eye Only - 25 Year Old Woman902 viewsInitial visit (June 11, 2011): 2 days of vision loss right eye. Wedge suddenly of VA loss OD, too dardkto see through. No flashes or floaters. VA 20/20 OU.
|
|

Twig Branch Retinal Vein Occlusion - Recurrent Macular Edema with extended interval Lucentis Therapy after first 6 monthly Injections902 views39-year-old man has a macular branch retinal vein occlusion with macular edema. He had an excellent response to Lucentis for his first 6 treatments. He was last here 6 weeks ago and his vision seems OK to him. OD 20/40.
|
|

Retinal Detachmet902 views
|
|

Radioactive Plaque Placement for Choroidal Melanoma Transillumination of Globe to Localize Melanoma 901 views
|
|

Ruptured Retinal Arterial Macroaneurysm - Submacular Hemorrhage - Vision 20/400 never recovered - Hypertension 205/94901 views
|
|

Central Areolar Choroidal Dystrophy901 viewsVision loss from early 60's. This 78 year old woman has choroidal atrophy centrally.
|
|

Bilateral Diffuse Uveal Melanocytic Proliferation - BDUMP - Paraneoplastic Syndrome900 views80-year-old man vision loss for one year. He died about one year after these photos from Metastatic Poorly Differentiated Large Cell Carcinoma of unknown primary. He was a smoker.
|
|

Bilateral Diffuse Uveal Melanocytic Proliferation - BDUMP - Paraneoplastic Syndrome900 views80-year-old man vision loss for one year. He died about one year after these photos from Metastatic Poorly Differentiated Large Cell Carcinoma of unknown primary. He was a smoker.
|
|

Basal Laminar Drusen - Cuticular Drusen - Equatorial Drusen - 70 Year Old Woman - Photo Equator898 views70 year old woman has had macular drusen since her thirties and she said her sister has a similar problem. Recently the vision in the left eye has substantially declined. OD 20/16, OS 10/200.
|
|

Proliferative Diabetic Retinopathy - Moderate - mild NVD with NVE 897 viewsVenous beading, vascular loops and NVE are visible on photos
|
|

Fungal Endophthalmitis896 views65-year-old woman had chronic endophthalmitis in the left eye 1 day post-op vitrectomy.
|
|

Acute Non-arteritic Anterior Ischemic Optic Neuropathy Right Eye - Previous NA-AION left eye 896 views69-year-old man previously lost vision in the left eye from nonarteritic anterior ischemic optic neuropathy in 2006. About a week ago and noticed blurred vision in the inferonasal part of the vision in the right eye.
VISUAL ACUITY: Vision OD is 20/16, OS is 20/40
|
|

Multifocal Pattern Dystrophy896 views51 year old with normal vision - images look a lot like fundus flavimaculatus
|
|

Ocular Histoplasmosis both Eyes - Laser Right Eye Only 895 views58-year-old woman who lost vision as a child in the left eye from ocular histoplasmosis. She used to play in her attic and she was told by her pulmonary doctor that is probably where she picked it up. She had laser in the right eye for a leaky lesion back in 1990. OD 20/25, OS 20/200.
|
|

Band Keratopathy/Neurotrophic Ulcer895 viewsPatient comes in with blind painful left eye. Slit lamp photos shows corneal diffuse scarring, descemets folds, corneal striae, band keratopathy, left eye. Proceed with Jupiter contact lens fitting on the left eye.
|
|

branch retinal vein occlusion - fundus photo894 views70 year old woman with 20/80 vision from a branch retinal vein occlusion and macular edema. She has had laser treatment and intravitreal steroids. Her vision with further laser improved to 20/50.
|
|

Acute Zonal Occult Outer Retinopathy894 views45-year-old man noticed a few years ago peripheral vision blurriness in the left eye and also some central vision loss. Previous to that, as far as he knows, the two eyes were okay.
VISUAL ACUITY: OD: 20/20; OS: 20/40.
|
|

Psuedo-retinitis Pigmentosa - Bone Spicules One Eye - Probably Acute Zonal Occult Outer Retinopathy (AZOOR)894 views65-year-old woman has pseudoretinitis pigmentosa in the right eye only, most likely from acute zonal occult outer retinopathy. OD 20/25, OS 20/25
|
|

Sturge-Weber Encephalotigeminal Angiomatosis - Facial Hemangioma and Asymptomatic Ipsilateral Diffuse Choroidal Hemangioma894 views61-year-old man with Sturge-Weber syndrome with a hemangioma on the left side of his face.
VISUAL ACUITY: Vision OD is 20/50, PH 20/30; OS 20/80, PH 20/30. IOP: OD 16, OS 19.
|
|

Juxtafoveal Telangiectasis - MacTel - Retinal Telangiectasis - Both Eyes - Crystals893 views61-year-old man has idiopathic juxtafoveal retinal telangiectasis type II in both eyes OD is 20/40, OS is 20/25
|
|

Shotgun wound to face with Perforating Pellet - Final Vision 20/400 893 views18-year-old had a gunshot wound to the left eye. He had surgery on December 31st (1 week post injury) and February 4th and his vision has remarkably done well.
VISUAL ACUITY: Vision OS is 3/200.
|
|

Multiple Evanescent White Dot Syndrome - Acute Idiopathic Blind Spot Enlargement892 views33-year-old woman one week ago she awoke and saw a red spots flashing out of her right eye. She notices them to the right side, which is the temporal visual field out of the right eye, then they changed to bursts of white lights without colors and then she notices straight ahead a couple spots. She has headaches in the back of her head. OD 20/20, OS 20/20
|
|

Retinal Arterial Macroaneurysm - Increased Swelling after Laser 892 views65-year-old woman was seen in the office on January 12, 2011. She has noticed decreased vision in the right eye for the last two or three weeks. She has had some discomfort in both eyes as well. She has a history of low blood pressure, but she does have high cholesterol.
VISUAL ACUITY: OD 20/60
|
|

Hyperpigmentation of the Retinal Pigment Epithelium in Dry AMD892 views87-year-old woman has wet age-related macular degeneration in the left eye. Vision OD is 20/25, OS is 20/400
|
|

Angioid Streaks - Pseudoxanthoma Elasticum - Supressed CNVM892 views54-year-old woman had angioid streaks and macular degeneration in both eyes. She has had intravitreal Avastin in the right eye about every three months and her vision in that eye is good.
VISUAL ACUITY: Vision OD is 20/30, OS is 2/200
|
|

Old Retinal Detachment Repair with Silicone Oil892 viewsPatient comes in for eval on glaucoma. Patients VA in the right eye was CF in the right eye and 20/50. left eye. Fundus photography shows old retinal detachment with scattered laser scars in the periphery. Silicone oil visible in the macula as well.
|
|

Proliferative Diabetic Retinopathy - Vitreous Hemorrhage and Tractional Retinal Detachment Left Eye889 views52-year-old man has been diabetic for nineteen years developed substantial vision loss over the last month or two. OD 20/70, OS 20/200.
|
|

889 views
|
|

Reticular Macular Disease (Pseudo-drusen) Both Eyes - Wet AMD OS - Dry AMD OD InfraRed889 views84-year-old woman has wet age-related macular degeneration in the left eye and dry macular degeneration in the right eye. She takes the eye vitamins and her vision is stable since she was treated three months ago with Avastin. OD 20/50, OS 20/32
|
|

Proliferative Diabetic Retinopathy - Moderate - mild NVD with NVE 889 viewsVenous beading, vascular loops and NVE are visible on photos
|
|

CHRPE lesion in the left eye - Irregular pigmentation888 views63 year old female with normal vision and CHRPE lesion in the right eye.
|
|

Diabetic Retinopathy - Non-Perfusion - Possible Central Retinal Vein Occlusion888 views68-year-old woman OD 20/70, OS 20/200 CYSTOID MACULAR EDEMA, POSSIBLE EITHER OCULAR ISCHEMIC SYNDROME IN THE RIGHT EYE OR OCCULT CENTRAL RETINAL VEIN OCCLUSION IN THE RIGHT EYE,S EVERE NON-PerfUSION WITH DIABETIC RETINOPATHY IN THE LEFT EYE.
|
|

Hemi Central Retinal Vein Occlusion 35 year old non-compliant man888 views35-year-old man hazy vision in his left eye for about the last three days. OD 20/20, OS 20/30
|
|

Stargardt's Disease - Macular Dystrophy - 69 Year Old African American Male - 20/200 both eyes888 views69-year-old man has had vision loss in both eyes starting 20 years ago. He was diagnosed at one point with Stargardt’s macular dystrophy. When I saw him, he had retinal atrophy in each eye.
Vision is 20/200 in each eye
|
|

Toxocariasis887 views15-year-old one year ago had pink eye then her vision has been abnormal. She recently went for a drivers’ test and failed, OD: 20/80; OS: 20/20.
|
|

Radioactive Plaque Placement for Choroidal Melanoma Transillumination of Globe to Localize Melanoma 887 views
|
|

Juxtafoveal Retinal Telangiectasia (Telangiectasis) - MacTel - Striking Gray Ring in Macula887 views59-year-old woman decreasing vision in the right eye for a few years. She has had diabetes for five years. OD 20/100, Pinhole 20/40. OS 20/20
|
|

Retinal Detachment with Macula Detached.887 viewsPatient went to the ER over the weekend with loss of vision in the right eye. VA was count fingers in the right eye. Noticed a curtain in the right eye. Horseshoe tear was seen at 10-o'clock temporally, right eye. Proceeded with surgery the next day.
|
|

Optic Nerve (Disc) Drusen - Spectral Domain Optical Coherence Tomography Line Scan887 views34 Year Old woman no headaches normal vision
|
|

Serpiginouse Choroiditis (Chorioretinitis) - Acute Right Eye - Old Left Eye VA 20/25 OD , 20/50 OS886 views63-year-old woman has serpiginous choroiditis (date - March 2011). The right eye has not been previously involved, and then she noticed new onset floaters in the right eye for the last two weeks. Her vision in the right eye is hazy because of that.
VISUAL ACUITY: Vision OD is 20/25, OS is 20/50
|
|

Stargardt's Disease - Macular Dystrophy - 69 Year Old African American Male - 20/200 both eyes886 views69-year-old man has had vision loss in both eyes starting 20 years ago. He was diagnosed at one point with Stargardt’s macular dystrophy. When I saw him, he had retinal atrophy in each eye.
Vision is 20/200 in each eye
|
|

Superior Retinal Detachment - Bullous - Macula-off886 views70-year-old man noticed a shadow creeping over the vision in the left eye and he no longer sees well out of that eye. He had cataract surgery two years ago and a YAG capsulotomy six months ago.
VISUAL ACUITY: OD 20/20, OS 1/200
|
|

Old BRAO twig with plaque884 views81-year-old woman Her left eye is amblyopic. Her right eye was doing fine until about last Sunday, which is five days ago. She had a change in vision where for five minutes she saw a shadow in her side vision out of the right eye. She describes it as being more up into the left. It lasted for just a brief time and then went away. She has had atrial fibrillation since January of 2008. She is on Coumadin for that. She is diabetic for eleven years. OD is 20/25, OS is 20/60. IOP: OD 15, OS 18.
|
|

Radioactive Plaque Placement for Choroidal Melanoma Transillumination of Globe to Localize Melanoma 884 views
|
|

Cilia and Cement Intraocular Foreign Body884 viewsConstruction worker jack-hammering 3 months prior to pictures. Asymptomatic. 20/20 OU. Corneal wound seen superiorly (not in pictures)
|
|

Nonprolific Diabetic Retinopathy with Circinate Ring884 viewsNonprolific Diabetic Retinopathy with Circinate Ring
|
|

50 Year Old woman with Congenital Retinal Vascular Tortuosity - Normal Vision884 views
|
|

Peripheral Iridotomy884 viewsSlit lamp photo of peripheral iridotomy for narrow angles. A hole was place at 10-o'clock superior temporally.
|
|

Myopic CNVM - Wet - rx Avastin for 1 year883 views55-year-old woman OD is 20/40, OS is 20/20. There is a hyperpigmented disc diameter choroidal neovascular membrane with fluid touching the fovea.
|
|

Gyrate Atrophy - 15 year old male - 20/25 vision both eyes - Positive Family History883 views15 year old male was diagnosed with “retinitis pigmentosa†at age seven. The patient reports that his night vision is poor. He reports he does not notice a visual field change. He reports that his maternal grandfather has lost vision and a cousin has lost vision as well. He reports he has an uncle with some visual changes.
The most significantly affected relative is a 26-year-old legally blind cousin.
20/25+ OD, 20/25 OS.
|
|

Hyperpigmentation of the Retinal Pigment Epithelium in Dry AMD883 views87-year-old woman has wet age-related macular degeneration in the left eye. Vision OD is 20/25, OS is 20/400
|
|

Punctate Inner Choroidopathy - PIC and Choroidal Neovascular Membrane - Right Eye - SD OCT883 views34-year-old woman with a change in vision in the right eye about eight days ago. Her vision was hazy and she saw waviness in the vision. She does have a history of aches and pains and she was diagnosed with Sjogren’s and 2 months ago she had some fevers and some sinus drainage and that went on for about two months. She is a moderate myope. OD 20/25, OS 20/20.
|
|

Retinal Pigmintosa883 views28-year old female with no light perception in the right eye.
|
|

Pattern Dystrophy - Adult Vitelliform Macular Degeneration882 views72-year-old woman 2 months post ECCE with poor vision since surgery especially left eye.
VISUAL ACUITY: OD 20/50, OS 20/200
|
|

Endophthalmitis882 views
|
|

Geographic Atrophy 20/160 Vision881 views84-year-old woman has age-related macular degeneration in both eyes with foveal atrophy. She also has a central retinal vein occlusion
in the left eye for which she had intravitreal Kenalog and finally chorioretinal anastomosis laser a year
ago. VISUAL ACUITY: Vision OD is 20/160, OS is 7/200.
|
|

Fundus Flavimaculatus - Stargardt Disease - 20/50 OD 20/200 OS 61 Year old Color Photo881 views61-year-old decreasing vision for about the last five years. OD 20/50, OS 20/200.
Pisciform Lesions and Macular Atrophy
|
|

Subretinal Perfluoro-n-octane Droplets - Red Free881 viewsSubretinal Perfluoro-n-octane droplets
|
|
| 17726 files on 178 page(s) |
 |
 |
 |
 |
 |
10 |  |
 |
 |
 |
|